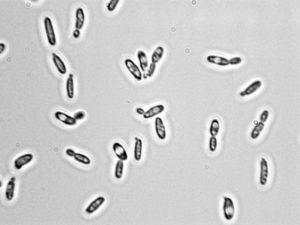
image
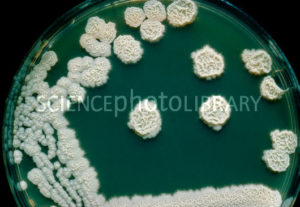
image
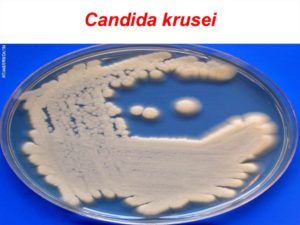
image

Кандида крузер
Редким подвидом грибов рода Candida является Candida krusei. Споры этих грибов находятся в почве, воздухе, продуктах питания. Заболевание поражает ротовую полость, пищевод, слизистые мочеполовых органов. Лечение кандидоза усложняется устойчивостью Кандиды krusei к противогрибковым медпрепаратам, поэтому болезнь часто переходит в хроническую форму.
Причины заболевания
Существует 150 подвидов грибка Candida. Только 6 из них поражают человеческий организм. В 1% случаев возбудителем болезни является Кандида krusei.
Candida krusei представляет собой крошечный микроорганизм. Он не содержится в составе микрофлоры здорового человека. На фоне ослабленного иммунитета возбудитель инфекции поражает слизистые оболочки ЖКТ, носоглотки, репродуктивных органов и мочевой системы. К причинам развития грибковой инфекции относятся:
- вич-инфекции;
- злокачественные новообразования;
- болезни эндокринной системы — сахарный диабет;
- прием антибиотиков или стероидных препаратов;
- дисбаланс гормональной системы;
- нехватка витаминов и микроэлементов;
- истощение организма;
- незащищенный половой акт;
- несоблюдение правил личной гигиены;
- раны и царапины на кожных покровах.
Основные симптомы
Выделения из влагалища имеют резкий неприятный запах.
Симптомы заболевания зависят от места локализации грибка, быстроты его распространения и области поражения. Характерным признаком заболевания является нарушение баланса микрофлоры слизистых оболочек. К основным симптомам относятся:
- белый налет на слизистых оболочках;
- резкий специфический запах;
- сильный зуд в области поражения;
- покраснение слизистых оболочек;
- эрозии на поврежденных участках;
- боль и жжение при глотании, мочеиспускании, половом акте;
- белые творожистые выделения из влагалища;
- налет белого цвета на головке полового члена;
- уретрит, баланит.
Методы диагностики
Основной задачей диагностических процедур является определение возбудителя болезни. Методами диагностики Кандиды крузеи являются:
- Микроскопия мазка выделений. Определяет наличие спор грибка в соскобе из очагов поражения.
- Бактериологический посев. Изучает морфологию грибка и его чувствительность к противогрибковым препаратам.
- Метод ПЦР. Подтверждает наличие в соскобе дрожжеподобного грибка и определяет его видовую принадлежность.
В чем опасность кандиды крузеи?
Ослабленная иммунная система не в состоянии остановить активный рост грибка.
Кандида крузеи обладает способностью создавать биопленку — матрицу грибов, защищенных от иммунной системы.
Такие колонии грибковой инфекции способны противостоять большинству противогрибковых препаратов. Поэтому заболевание часто переходит в хроническую форму кандидоза.
В человеческом организме грибки Candida крузеи:
- вызывают аллергические реакции;
- выделяют токсины, поражающие печень;
- подавляют иммунную систему;
- ослабляют организм;
- инфицируют плод во время беременности.
Лечение Кандиды крузеи
Лечение Candida крузеи зависит от места локализации грибка и симптомов заболевания. Возбудитель болезни обладает повышенной устойчивостью к противогрибковой терапии. Поэтому лечить грибковую инфекцию нужно в комплексе. Основные медпрепараты для борьбы с Candida крузеи представлены в таблице:
| «Цитросепт» | Натуральный состав оказывает антибактериальное действие, предотвращает развитие патогенной флоры |
| «Клотримазол», «Кетоконазол», «Тиоконазол» | Обладают мощным противогрибковым эффектом, предотвращают развитие грибковых инфекций |
| «Наттокиназа», «Люмброкиназа» | Восстанавливают функциональность эндокринной, сердечно-сосудистой и иммунной системы |
| «Лактоферрин» | Уничтожает вирусные грибковые инфекции |
| «Леворин», «Нистатин» | Антибиотики природного происхождения разрушают клетки грибков |
| «Итраконазол», «Амфотерицин В», «Каспофугин» | Оказывают эффективное противогрибковое действие при кандидозе пищевода |
| «Энтерол» | Нормализует микрофлору кишечника и обладает выраженным этиопатогенетическим действием |
| «Бетадин», «Хлоргексидин» | Обеззараживают пораженные участки, предотвращают распространение грибковой инфекции |
| «Хилак форте», «Линекс» | Нормализуют микрофлору ЖКТ |
Лечение кандидоза, вызванного грибком Кандида крузеи, проводится только по назначению врача.
Для быстрой и эффективной ликвидации грибковой инфекции рекомендуется отказаться от сахара в питании, и придерживаться строгих правил личной гигиены. Как дополнительный метод борьбы с грибком Кандида крузеи используются средства народной медицины.
Отвары из календулы, ромашки, коры дуба оказывают противовоспалительное действие, и являются сильным природным антисептиком. Для укрепления иммунитета и организма в целом рекомендуется принимать витаминные комплексы.
Источник: http://EtoGribok.ru/na-tele/raznovidnosti/candida-krusei.html
Кандида Крузеи — что это такое: лечение кандиды тропикалис
За последнее двадцатилетие количество грибковых инфекций резко возросло. Это обусловлено значительным увеличением числа пациентов с иммунодефицитом.
Основной возбудитель кандидоза – Кандида альбиканс, глабрата и тропикалис. Чуть реже встречается Кандида крузеи, Candida parapsilosis.
По статистике, Кандида крузеи встречается в 1-3% от всех картин, в большинстве случаев в хронической форме, что связано с неправильной первичной диагностикой.
Виды грибков Кандида: отличительные характеристики
Candida spp. – обширная группа условно-патогенных микроорганизмов, которые обнаруживаются на слизистой оболочке у более 50% здоровых людей. Поэтому в медицинской практике различают патологическое состояние – кандидоз, а также колонизацию слизистых оболочек.
В первом случае говорят о патологии, которая требует применения противогрибковых препаратов для снижения активности и количества грибковых микроорганизмов. Второй вариант – относительная норма, не требующая медицинского вмешательства на фоне отсутствия характерных признаков поражения грибками.
Стоит знать: существует около 180 подвидов грибков Кандида. Только 6 из них приводят к развитию патологического процесса. В 1% диагностируется активность Candida krusei.
Особенности Кандиды крузеи
Грибок подвида крузеи предстает крошечным микроорганизмом, вызывающим молочницу половых органов, ротовой полости и аллергические реакции. У детей чаще всего диагностируется стоматит, который поражает ротовую полость. У взрослых в большинстве случаев встречается урогенитальная форма.
Лечение всегда нужно начинать с глубокой диагностики и 100% установления подвида микроорганизма. Обычные противогрибковые препараты отличаются низкой эффективностью, практически не воздействуют на паразита, вследствие его чрезмерной устойчивости.
Если неправильно поставить диагноз и начать терапию стандартными противогрибковыми средствами, то вероятность преобразования молочницы в хроническую форму составляет свыше 95%.
Особенности Кандида тропикалис
Кандида тропикалис встречается примерно в 10-15% от всех клинических картин. Клинические проявления схожи с заражением Кандида альбиканс. Находится в желудочно-кишечном тракте любого здорового человека, служит пищей для полезных бактерий.
При наличии провоцирующих факторов увеличивается активность патогена, вследствие чего развивается заболевание. К факторам для Сandida tropicalis относят:
- Опухолевые новообразования;
- Инфекционные процессы;
- Неправильное питание;
- Частые стрессы;
- Применение гормональных лекарств.
Опасность Кандида тропикалис заключается в том, что при росте грибок поражает многие внутренние органы. Соответственно, симптоматика характерна пораженной зоне. Для установления вида паразита требуется дифференциальная диагностика.
К сведению, Кандида тропикалис отличается меньшей агрессивностью в сравнении с Кандида альбиканс.
Другие виды и их отличительные характеристики
Кандида Parapsiosis чаще встречается на территории Европы. Приходится примерно на 10% пациентов с грибковыми инфекциями. Кандида Lusitaniae является очень редким подвидом, принимает «участие» в заражении крови и при пиелонефритах.
Каждый подвид имеет свои характеристики, соответственно, одни более опасны и агрессивны, способны спровоцировать многочисленные осложнения, в отличие от других. Способностью укореняться в организме отличаются виды:
- Тропикалис;
- Альбиканс;
- Кандида dubliniensis.
Некоторые подвиды могут создавать определенную пленку, которая является препятствием для их уничтожения. В частности, она защищает патогенные микроорганизмы от атаки иммунной системы. Этой способностью обладает Кандида крузеи.
Что провоцирует рост грибков в организме?
В настоящий момент выделяется обширный перечень причин, которые приводят к развитию молочницы у взрослых и детей. Среди них выделяют неправильное питание – злоупотребление рафинированными углеводами и сахарным песком, алкогольные напитки, курение.
Антибактериальная терапия часто провоцирует размножение грибков разных подгрупп. Антибиотики угнетают полноценную микрофлору кишечника, вследствие чего наблюдается рост патогенной флоры.
Сочетание неправильного питания и противозачаточных лекарств значительно увеличивает вероятность появления кандидоза. От молочницы застраховаться невозможно, однако можно убрать факторы, которые к ней приводят.
Предпосылки развития грибковой патологии:
- Применение стероидов;
- Гормональный дисбаланс;
- Дефицит питательных компонентов, витаминов и минералов;
- Истощение организма вследствие диеты либо оперативного вмешательства;
- Длительное воздействие химических веществ;
- Сахарный диабет 1 и 2 типа;
- Несоблюдение элементарных правил гигиены;
- Частая смена половых партнеров без должной защиты.
Спектр заболеваний, вызываемых Candida spp., достаточно обширен. Проявление инфекций варьируется от поверхностной молочницы кожного покрова с поражением слизистой, до системного поражения внутренних органов.
Клиническая картина кандидоза
В подавляющем большинстве клинических картин Кандида крузеи поражает слизистую ротовой полости, пищевода либо половые органы. В зависимости от места колонизации патогенных грибков складывается клиническая картина.
Вагинальный кандидоз: симптомы
Симптомы вагинальной молочницы у женщин достаточно типичны. Они могут проявляться все вместе одновременно, либо изолированно. Наиболее распространенные признаки:
- Зуд. Начиная от легкой интенсивности и заканчивая сильной выраженностью. Его наличие обусловлено состоянием иммунной системы, острой или хронической формой патологии.
- Жжение указывает на интенсивность воспалительного процесса. Часто сопровождается краснотой и отеком слизистой вульвы.
- Выделения белого цвета, похожие на творог. Характеризуются специфическим запахом.
- Боль во время полового акта, неприятные ощущения в процессе мочеиспускания.
Важно: если выделения при молочнице имеют розоватый или зеленоватый оттенок, это свидетельствует о присоединении другого инфекционного процесса.
Кандидоз в полости рта: основные клинические проявления
Как правило, молочница в ротовой полости развивается под воздействием двух и более провоцирующих факторов. Симптоматика базируется на общем состоянии и иммунном статусе пациента. В медицинской практике выделяют острую и хроническую форму.
В первом случае клиника яркая и интенсивная, во втором варианте патология характеризуется обострениями и ремиссиями.
Грибковая инфекция во рту протекает на фоне образования белого налета на внутренней поверхности щек, на языке и небе. Поначалу он легко снимается, например, ватной палочкой. Но со временем это сделать труднее. После снятия обнаруживается язвочка, иногда проявляется кровоточивость.
Вследствие постоянного раздражения в ротовой полости у пациентов наблюдается зуд и жжение во рту. Увеличивается дискомфорт во время разговора, приема пищи и т.д. В большинстве случаев у больных возрастает температура тела до субфебрильных цифр.
Молочница пищевода
Кандидоз пищевода – наиболее трудно определяемое заболевание среди всех молочниц. У 30% заболевших практически не имеется каких-либо тревожных симптомов. Многие и не догадываются, что в организме протекает патологический процесс.
У оставшихся 70% заболевших людей выявляются симптомы:
- Изжога, понижение аппетита;
- Нарушения в процессе глотания пищи;
- Болевой синдром во время приема пищи;
- Боли в области грудной клетки;
- Частые приступы тошноты, иногда рвота;
- Повышение температуры тела;
- Расстройство работы пищеварительного тракта.
Боли во время приема пищи бывают незначительные и интенсивные. В последнем случае могут стать причиной обезвоживания организма. В рвотных массах присутствуют белесые пленки, являющиеся характерным признаком кандидоза пищевода.
Если для избавления от Кандида альбиканс существует огромный ассортимент лекарственных препаратов, то лечить Кандиду крузеи не так просто. Во-первых, грибок крайне устойчив к противогрибковому воздействию, во-вторых, лечение должно быть комплексным, одновременно направленным на уничтожение патогена и излечение от причины, спровоцировавшей заболевание.
К сведению, противогрибковый препарат Флуконазол не воздействует на Кандида крузеи, его применение в этом случае бесполезно.
Препарат имеет растительную природу, включает в состав биофлавоноиды и аскорбиновую кислоту. Выпускается в виде капель и капсул. Обладает антибактериальным, противовирусным и противогрибковым свойством.
Способ применения:
- При легкой форме молочницы принимают по 20-30 капель три раза в сутки;
- В тяжелых случаях дозировка удваивается (только по назначению лечащего врача).
При кандидозе пищевода назначают Итраконазол, Каспофунгин. Дозировка определяется индивидуально. В дополнение назначают Энтерол – средство, помогающее нормализовать микрофлору кишечника.
Во время терапевтического курса рекомендуется пересмотреть свой рацион, исключить сахар, рафинированные углеводы, маринады, копчености. Эти продукты способствуют росту болезнетворных агентов, что затрудняет процесс лечения.
Источник: https://IDermatolog.ru/kandidoz/kandida-kruzei.html
Кандида разная бывает
Многие люди борются с инфекцией Кандида, но не знают, что это инфекция может быть связана с разными микроорганизмами. Ведь существует 150 подвидов Candida, правда и к счастью, только 6 из них, как правило, связаны с проблемной инфекцией в организме человека.
Врага надо знать в лицо!
1. Кандида Albicans
На сегодняшний день наиболее широко известный и составляет около 50% случаев заболеваний по всему миру.
2. Кандида Tropicalis
Является причиной заболеваний в 15 — 20% случаев. Но не так агрессивна, как Candida Albicans.
3. Кандида Glabrata
Число заболеваний составляет 15 – 20% случаев.
4. Кандида Parapsiosis
Число заболеваний 15 – 20% случаев, особенно в Европе.
5. Кандида Krusei
Очень редкий подвид, как правило, только около 1% случаев.
6. Кандида Lusitaniae
Очень редкий подвид, как правило, участвует в септицемии (заражении крови) и при пиелонефритах.
Многие факторы влияют на то, что Candida вызывает человеку неприятности. Об этом я писала в статье «Грибок кандида» Если вас интересует эта тема, и вы пропустили, не читали эту статью, то рекомендую вам ее прочесть.
Если вы не здоровы, если ваша иммунная система ослаблена, то Candida начинает «процветать» в вашем организме.
Поддержка здоровой иммунной системы является ключом к поддержанию любой оппортунистической инфекции в страхе, и это верно в случае с Candida тоже.
Некоторые виды Candida являются более опасными, чем другие
Каждый из этих видов имеет конкретный набор свойств, что означает, что некоторые из них гораздо более вирулентными, чем другие.
Вы можете узнать больше об их вирулентности и способности заражать организм человека, познакомившись с некоторой информацией о них
На что способны разные подвиды Candida?
1. Они различаются по их способности сформировать гифы
Гифы – это что-то типа «пальцев», которые вторгаются в ткани и глубоко укореняют инфекции.
На это способны три основных вида этого грибка: Candida Albicans, Candida tropicalis и другой тип, называемый Кандида dubliniensis;
2. Некоторые из них способны создавать биопленку
3. Способность производить фермент фосфолипазы
4. Способность производить фермент протеиназы
Этот фермент растворяет белки и функционирует таким же образом, как фосфолипазы.
Опять же, Candida Albicans производит высокие количества этого фермента.
Как узнать, какой подвид Candida причиняет вам неприятности?
Лучший способ определить, какие подвиды Candida вызывает симптомы заболевания – сделать анализ.
Тщательный анализ позволяет определять патогенные бактерии.
Candida Albicans на сегодняшний день наиболее распространенный вариант Candida.
Но конкретный тип, от которого вы страдаете, зависит от ряда факторов:
1.Географическое расположение является одним из примеров.
В самом деле, Candida parapsilosis находится гораздо чаще в Европе.
2. Насколько сильна иммунной системы и других условий, которые вы можете иметь.
Например, Кандида glabrata, скорее всего, влияет на тех, кто борется со СПИДом, и, следовательно, несет ответственность за более высокую смертность, чем какие-либо другие виды Candida.
У пациентов, получавших дифлюкан в течение длительных периодов времени, они могут быть восприимчивы к резистентным штаммам Candida, как krusei.
Вы поняли, почему долгое лечение дифлюканом не всегда бывает успешным?
Наконец, Кандида parapsilosis также часто встречается у лиц с ослабленным иммунитетом и обладает высокой устойчивостью к противомикробным препаратам.
Что надо знать, если вас беспокоит Candida?
1. Подумайте о других проблемах с вашим здоровьем.
Общая вирулентность штаммов этого грибка зависит от многих вещей, в том числе от существующих условий:
- Общего уровня иммунитета.
- От места, где кандида процветает.
- От стадии инфекции (если вы заметили ее рано, то вылечить ее будет легче).
- Если вы принимаете лекарства, то они могут значительно повлиять на факторы риска.
Известно, что при приеме стероидов может развиваться Candida krusei.
Если вы не можете определить какие-либо конкретные факторы, относящиеся к вашей иммунной системе или лекарствам, наиболее вероятно, что у вас есть инфекция Candida Albicans.
Candida Albicans присутствует в большинстве случаев и является одним из наиболее агрессивных видов.
Если вы страдаете от одного из типов Candida, которые создают сильные биопленки (например, krusei или tropicalis), то это будет иметь последствия для ваших самых эффективных методов лечения.
В таких случаях необходимо рассмотреть вопрос об использовании дополнений, которые нарушают биопленки, такие как Nattokinase или Lumbrokinase. Это не безопасные ферменты, лечиться надо под контролем врача!
В конечном счете, основное лечение для большинства инфекций Candida сводится к трем вещам:
1. Взять хороший пробиотик и заселить им свой кишечник.
2. Использовать противогрибковые препараты для уничтожения Кандиды.
3. Отказаться от использования сахара в питании, который любят эти грибы и используют его для своего роста.
Если вы хотите своевременно получать новые уникальные статьи о здоровом питании, то подпишитесь на новости блога..
Кандида разная бывает.
Источник: https://pishhaizdorove.com/kandida-raznaya-byvaet/
Возбудители кандидоза (Candida albicans / glabrata / krusei / parapsilosis и tropicalis), количественное определение ДНК (соскоб)
» [«cito_period»]=> NULL [«cito_period_max»]=> NULL [«cito_period_unit_name»]=> NULL [«group_id»]=> string(5) «25397» [«id»]=> string(4) «2381» [«url»]=> string(62) «vozbuditeli-kandidoza-kolichestvennoje-opredelenije-dnk_170003» [«podgotoa»]=> string(1358) «
Условия подготовки определяются лечащим врачом.
Внимание: Для получения достоверных результатов анализы должны проводиться до приема противогрибковых препаратов или не менее, чем через 2 недели после последнего приема.
Не рекомендуется взятие биоматериала ранее 24-48 часов после полового контакта.
Соскоб из уретры (для мужчин): рекомендуется сдавать через 2 часа после последнего мочеиспускания.
Соскоб из урогенитального тракта (для женщин) не следует брать:
- во время менструации;
- ранее 5 дней после использования вагинальных свечей, тампонов или спермицидов;
- после вагинального исследования (УЗИ малого таза, кольпоскопия), спринцевания;
» [«opisanie»]=> string(4514) «
Метод исследования: ПЦР
Грибы рода Candida у значительного числа здоровых людей колонизируют слизистые оболочки желудочно-кишечного тракта, ротовой полости, урогенитального тракта и поверхность кожи, не вызывая развития патологического процесса. Но при нарушениях иммунитета вызывают воспалительные процессы.
Наиболее частым возбудителем кандидоза слизистых оболочек урогенитального тракта является C.albicans. В 15–25% случаях кандидоз вызывается C.tropicalis, C.parapsilosis, Candida glabrata, C.krusei, C.guilliermondii, C.kefyr.
Исследование позволяет выявить степень обсемененности урогенитального тракта и дифференцировать виды Candida albicans и non-albicans (Candida glabrata, C.parapsilosis и tropicalis , C.krusei), последние проявляют устойчивость к некоторым широко применяемым антимикотическим препаратам.
Урогенитальный кандидоз у мужчин протекает в виде баланопостита и уретрита, вызывая воспаление крайней плоти, головки полового члена и передней уретры. У женщин наиболее частая форма урогенитального кандидоза – кандидозный вульвовагинит, сопровождающийся воспалением слизистой влагалища и вульвы и выделениями из влагалища.
Показания к исследованию:
- Обследование при подозрении на грибковую инфекцию;
- Контроль эффективности терапии.
Интерпретация результатов:
Референсные значения (вариант нормы):
| ДНК Candida albicans/ glabrata/krusei / parapsilosis и tropicalis (количественное исследование) | ||
| ДНК Candida albicans | Не обнаружено | ГЭ/мл |
| ДНК Candida glabrata | Не обнаружено | ГЭ/мл |
| ДНК Candida krusei | Не обнаружено | ГЭ/мл |
| ДНК Candida parapsilosis и tropicalis | Не обнаружено | ГЭ/мл |
Выявление ДНК Candida свидетельствует о наличии возбудителя. Но необходимо учитывать наличие клинических проявлений заболевания и высокую частоту встречаемости дрожжеподобных грибов Candida у клинически здоровых лиц.
Обращаем Ваше внимание на то, что интерпретация результатов исследований, установление диагноза, а также назначение лечения, в соответствии с Федеральным законом № 323-ФЗ «Об основах охраны здоровья граждан в Российской Федерации» от 21 ноября 2011 года, должны производиться врачом соответствующей специализации.
» [«serv_cost»]=> string(3) «795» [«cito_price»]=> NULL [«parent»]=> string(2) «25» [10]=> string(1) «1» [«limit»]=> NULL [«bmats»]=> array(1) { [0]=> array(3) { [«cito»]=> string(1) «N» [«own_bmat»]=> string(2) «12» [«name»]=> string(12) «Соскоб» } } [«within»]=> array(2) { [0]=> array(5) { [«url»]=> string(41) «urogenitalnyje-infekcii-u-muzhchin_170004» [«name»]=> string(273) «Урогенитальные инфекции у мужчин (N.gonorrhoeae / C.trachomatis / M.genitalium / T.vaginalis // U.parvum/urealyticum/M.hominis // C.albicans/glabrata/crusei/parapsilosis и tropicalis), количественное определение ДНК» [«serv_cost»]=> string(4) «2080» [«opisanie»]=> string(0) «» [«catalog_code»]=> string(6) «170004» } [1]=> array(5) { [«url»]=> string(42) «urogenitalnyje-infekcii-u-zhenshhin_170005» [«name»]=> string(318) «Урогенитальные инфекции у женщин (N.gonorrhoeae / C.trachomatis / M.genitalium / T.vaginalis // U.parvum/urealyticum/M.hominis // C.albicans/glabrata/crusei/parapsilosis и tropicalis // Бактериальный вагиноз), количественное определение ДНК» [«serv_cost»]=> string(4) «2940» [«opisanie»]=> string(0) «» [«catalog_code»]=> string(6) «170005» } }}
Источник: https://www.cmd-online.ru/analizy-i-tseny/vozbuditeli-kandidoza-kolichestvennoje-opredelenije-dnk_170003/
9 мифов о дрожжевой инфекции у женщин
Вопреки распространенности или благодаря ей, инфекция, вызываемая дрожжевыми грибками Candida albicans, C.krusei, C.glabrata, C.pseudotropicalis, которую в обиходе часто называют «молочницей», постепенно «обросла» многочисленными мифами. Причем отделить факт от вымысла непосвященному в премудрости медицины зачастую довольно трудно.
Мы расскажем, почему интимные отношения не являются главным источником заражения, объяснит, почему внеочередное вагинальное кровотечение не входит в число симптомов патологии и раскроет несколько других «популярных» заблуждений по поводу дрожжевой инфекции.
Миф № 1: интимные отношения являются основной причиной заражения
Согласно недавним опросам, более 80% женщин в возрасте от 16 до 24 лет считают, что сексуальные отношения является основной причиной дрожжевой инфекции. На самом деле, это неверно.
Дрожжевые грибки окружают каждого человека, обитают в натуральных продуктах питания, населяют слизистые оболочки.
Их обнаруживают не только в ротовой полости, на кожных покровах, в кишечнике людей, во влагалище женщин, но и в плаценте, околоплодной жидкости, оболочках пуповины.
Дрожжевая инфекция, как правило, бывает спровоцирована ослаблением иммунитета. Оно, в свою очередь, возникает на фоне:
- применения гормональных контрацептивов с высокими дозами эстрогенов;
- приема антибиотиков;
- беременности;
- терапии стероидными препаратами;
- сахарного диабета;
- инфекционных патологий;
- ВИЧ;
- менструальных кровотечений и некоторых других факторов.
Миф №2: если дрожжевая инфекция появилась — это на всю жизнь
Статистика демонстрирует, что 67% женщин в возрасте от 16 до 24 лет считают, что эффективных лекарств от дрожжевых инфекций нет.
На самом деле, существуют лекарственные препараты (системные и местные) для устранения неприятных симптомов и профилактические средства, которые предупреждают их появление.
Советы
- Проконсультируйтесь с гинекологом, чтобы подобрать препараты для профилактики или лечения дрожжевых инфекций.
- Не занимайтесь самолечением! Врач подберет адекватную терапию, составит схему лечения, в зависимости от объективного состояния, с учетом имеющихся противопоказаний, возможных побочных эффектов.
Миф № 3: следует исключать любые контакты с больными
59% женщин в возрасте от 16 до 24 лет считают, что дрожжевые инфекции очень заразны и передаются даже при прикосновениях, поэтому следует избегать любых контактов с больным человеком. Но это не соответствует действительности.
Как было сказано выше, патологические симптомы бывают вызваны дисбалансом естественной микрофлоры влагалища. Заражение может произойти при незащищенном сексе, в том числе при оральном. Но обычное рукопожатие, объятия и прочие контакты не могут повлиять на микрофлору слизистых урогенитальной области.
Миф № 4: привычка держать ноутбук на коленях может спровоцировать патологию
Более 50% молодых женщин обвиняют привычку держать работающий ноутбук на коленях в том, что появляются зуд, жжение и прочие неприятные симптомы в области наружных половых органов, объясняя это длительным нагреванием. Но это — заблуждение.
Данная привычка, действительно, не относится к числу хороших. Однако тепло, излучаемое работающим ноутбуком, не имеет никакого отношения к вспышкам дрожжевой инфекции.
Миф № 5: использование презерватива — гарантия профилактики
30% женщин молодого возраста уверены, что защищенные интимные отношения — гарантия от заражения.
Утверждение справедливо, если речь идет о заболеваниях, передающихся половым путем. Но к сожалению, использование презервативов, не может гарантировать защиту от дрожжевых инфекций.
Так как дрожжевые грибки в небольшом количестве в норме обитают на слизистых урогенитальной области здоровых представительниц прекрасного пола.
А значит, даже при отсутствии половы контактов, женщина может иметь молочницу.
Миф № 6: со мной этого не случится
Дрожжевая инфекция — это очень распространенная патология.
Молочница не понаслышке знакома трем из четырех женщин, которые сталкивались с назойливым зудом в области половых органов, жжением, творожистыми выделениями из влагалища и прочими неприятными симптомами хотя бы однажды на протяжении жизни. Почти половина представительниц прекрасного пола встречается с ней дважды на жизненном пути.
Миф № 7: нет способа снизить риск возникновения молочницы
Многие считают, что предупредить молочницу невозможно. Но любая женщина может предпринять профилактические меры, чтобы снизить риск.
Советы
- Соблюдайте личную гигиену, используя специальные моющие средства для интимной области.
- Избегайте плотной одежды, которая провоцирует избыточное потоотделение.
- Не оставайтесь в мокрых купальных костюмах.
- Носите дышащее хлопковое нижнее белье.
- Ответственно подходите к выбору сексуального партнера.
Миф № 8: вагинальное кровотечение (не менструальное) — симптом молочницы
Инфекция, вызванная дрожжевыми грибками, сопровождается широким спектром симптомов, но вагинальное кровотечение не входит в их число.
Совет
Если оно появилось и не является обычным менструальным кровотечением, необходимо обратиться к врачу.
Миф № 9: молочница не опасна
Опасность представляет уже само заблуждение. Дело в том, что дрожжевая инфекция может иметь тяжелые последствия и весьма нежелательные осложнения.
- Она ослабляет иммунитет и открывает «дорогу» другим патогенным микроорганизмам. К молочнице нередко присоединяются другие инфекционные заболевания.
- Частым осложнением инфекций, вызванных дрожжевыми грибками, является стеноз влагалища.
- Особенно опасен кандидоз урогенитальной области для беременных женщин. Он может привести к самопроизвольному выкидышу, преждевременному рождению ребенка, стать причиной малого веса новорожденного.
- Кроме того, молочница может стать причиной невынашивания беременностей.
Источник
Источник: https://formulazdorovya.com/1202725098356214041/9-mifov-o-drozhzhevoj-infektsii-u-zhenschin/
Дрожжеподобные грибы рода Кандида
Так устроен мир, что каждого из нас окружают тысячи микроскопических существ. Невооруженным глазом мы их не видим, но соприкасаемся с ними ежеминутно. Одни «невидимки» нам помогают, другие убивают, а третьи могут приносить, и вред, и пользу.
Дрожжеподобные грибы рода Кандида являются как раз такими микробами, которые не мешают нам жить счастливо, но в определенных ситуациях начинают вести себя агрессивно, вызывая заболевание кандидоз или молочницу. Потому что эти микроорганизмы не всегда приносят вред, их называют условно-патогенными.
Всего открыто 186 видов грибов из рода Кандида, но опасны лишь два десятка видов. О них пойдет речь в данной статье.
Род грибов Кандида: характерные особенности
Кандиды относятся к роду дрожжей. Большинство их видов являются совершенно безвредными, живут в теле чайного гриба, в кефире, в других кисломолочных продуктах, а также в ЖКТ человека, являя собой часть микрофлоры здорового кишечника. Грибы рода Кандида являются аэробами, то есть, ведут активную жизнь при наличии кислорода.
Они могут существовать в двух формах – дрожжевой и мицеллярной. В дрожжевой грибы представляют собой круглые или овальные бластоспоры и размножаются почкованием. В мицеллярной форме клетки грибов удлиняются, превращаясь в псевдомицелий. В отличие от истинного, в нем нет перегородок, но есть перетяжки.
На них располагаются бластоспоры, а на терминальных расширениях хламидиоспоры с двойной оболочкой. В мицеллярной форме грибы способны спариваться.
От других диморфных созданий грибы рода Кандида отличаются тем, что могут находиться в теле своего хозяина сразу в двух своих формах, а не менять их в зависимости от температуры среды.
Важное свойство кандид – они умеют ферментировать мальтозу и глюкозу.
Заболевание кандидоз, согласно последним исследованиям, вызывают примерно 20 видов этих грибов, а наиболее опасными являются C.Albicans (60%) и C.Tropicalis (20%). Остальные 18 видов распространены менее широко и значительного влияния на уровень заболеваемости кандидозом не оказывают.
Краткое описание патогенных видов
Наиболее широко встречаются грибы рода Кандида, называющиеся C.Albicans. Их носителями являются примерно 8 человек из 10. В основном эти грибы попадают в организм младенца при рождении и живут, не доставляя неудобств, в ротовой полости, в пищеводе и в кишечнике. У женщин они также являются частью микрофлоры влагалища. Именно этот вид кандид чаще всего повинен в возникновении кандидоза.
Второй опасный вид называется C.Tropicalis. Эти грибы способны проникать в кровь и с ее помощью заселять периферические органы. Последние исследования выявили особенность Кандиды C.Tropicalis работать в тандеме с Serratia marcescens и с Escherichia coli, и приводить к болезни Крона.
Не очень распространены, но считаются самыми опасными дрожжевые грибы рода Кандида вида C.Krusei. Они устойчивы к лекарству «Флуконазол», использующемуся при лечении грибковых инфекций, поэтому важно правильно дифференцировать вид патогенного грибка, поразившего больного.
Кандида вида C.Parapsilosis часто становится причиной сепсиса. Она способна инфицировать раны, особенно если в них попадают инородные предметы.
Виды грибов C.Rugosa и C.Lusitaniae и другие из рода Кандида встречаются крайне редко. Например, C.Lusitaniae в период с 1979 по 1990 года был выявлен только у 30 пациентов.
Пути инфицирования
Условно – патогенные дрожжеподобные грибы рода Кандида в процессе эволюции выработали механизмы, помогающие им вести паразитическое существование. Они способны длительно выдерживать замораживание и высушивание.
Попасть в организм человека они могут с немытыми и недостаточно обработанными продуктами питания, с грязными руками и другими предметами, например, грибы C.Parapsilosis инфицируют раны при проникновении в них инородных предметов, включая и непростерилизованные медицинские инструменты, а грибы C.
Glabrata с мочевыми или внутривенными катетерами. Чаще всего происходит инфицирование грибами вида C.Albicans, причем с первых минут жизни младенца. Такое случается во время родов, если влагалище роженицы заселено этими микробами. Есть также предположение, что C.
Albicans проникает в тело малыша еще на стадии эмбриона, так как грибы неоднократно обнаруживались в околоплодных водах. Если роженица входит в тот небольшой процент людей, не являющихся носителями грибов, ее малыш в течение первых лет жизни может заразиться ими через соску, игрушки и так далее.
Паниковать из-за этого не стоит, так как кандиды, попав в организм своего хозяина, ведут себя смирно, даже помогают ему, контролируя рост других патогенов.
Когда инфицирование грибами Кандида становится заболеванием
Человек может быть носителем этих микробов всю жизнь, оставаясь при этом полностью здоровым. Грибы рода Кандида становятся патогенными, только когда их размножение выходит из-под контроля. Причины:
— беременность;
— различные инфекции;
— обострение хронических болезней;
— гипо- или авитаминоз;
— длительное лечение антибиотиками;
— прием кортикостероидов;
— гормональные нарушения.
Основной причиной, вызывающей кандидоз, является низкий иммунитет. Это состояние может появиться во многих ситуациях, включая плохое питание, неблагоприятные условия проживания, частые стрессы.
Кроме того, внезапный рост грибов рода Кандида происходит при следующих сопутствующих заболеваниях:
— СПИД (или ВИЧ-инфицирование);
— сахарный диабет;
— туберкулез;
— болезни ЖКТ;
— болезни мочеполовой системы;
— гипотиреоз;
— некоторые болезни крови;
— вагиноз.
Факторы патогенности
Размеры одного гриба рода Кандида составляют всего 2-5 мкм, поэтому рассмотреть их можно только в микроскоп. Те белые или желтовато-сероватые пленочки, которые вырастают на агаре или налет, видимый на пораженных участках тела – это целые колонии грибов, насчитывающие сотни тысяч отдельных микроорганизмов.
Попав в организм хозяина, как ведут себя грибы рода Кандида? Исследования микробиологов показали, что каждый гриб стремится начать адгезию, то есть, плотно сцепиться, можно сказать, врасти в эпителиальные клетки человека. Это микробам удается тем легче, чем ниже иммунитет их жертвы, и чем выше у нее эндокринные нарушения.
Самый активный по части сцепления гриб вида C.Albicans. Попав на слизистые, он адгезируется в 100% случаев. Самый пассивный гриб вида C.Krusei. Он может вообще не закрепиться, то есть инфицирования не происходит.
При возникновении молочницы грибы рода Кандида в мазке, взятом из этих органов, обнаруживаются с высокой вероятностью, что дает возможность безошибочно поставить диагноз.
На начальном этапе адгезии грибы находятся в дрожжевой форме, но быстро перестраиваются, образуя длинные нити (гифы), которые легче проникают в поврежденные клетки хозяина, а фагоцитозу лейкоцитов подвержены меньше.
Закрепившись и освоившись, паразиты в процессе своей жизнедеятельности выделяют в организм хозяина различные яды:
— кандидотоксин (белок, действующий на базофилы и тучные клетки и вызывающий псевдоаллергическую реакцию);
— 6 типов низкомолекулярных токсинов (повышают проницаемость сосудов, снижают артериальное давление);
— липидные токсины (вызывают местную лейкоцитарную реакцию и приводят к появлению грануляционной ткани).
Кандидоз у детей
Как отмечено выше, грудные дети инфицируются кандидами либо в утробе матери, либо при родах в момент прохождения родовых путей. В дальнейшем гриб может попасть младенцу в ротовую полость с плохо обработанной соской, погремушками, с сосков инфицированной матери. Симптомы того, что малыш заразился молочницей, следующие:
— белый, похожий на творожок налет на язычке, на внутренней поверхности десенок и щечек;
— капризность;
— отказ от пищи.
Без лечения гриб продолжает расселяться и вскоре появляется и на губах младенца.
Грибы рода Кандида в кишечнике проявляются симптомами дисбактериоза, такими как:
— понос;
— вялость;
— температура;
— потеря в весе.
Понос у грудничков опасен тем, что влечет за собой быстрое обезвоживание, поэтому больной ребенок подлежит госпитализации. Только в условиях стационара можно оказать ему необходимое лечение (капельницы), чтобы предотвратить потерю жидкости.
Кроме органов ЖКТ и ротовой полости, молочница у малышей может проявляться на коже. В этом случае появляются не белые, а красные пятна, похожие на опрелости. Ребенок становится очень капризным, так как любые касания эрозий причиняют ему страдания.
Чаще всего кожный кандидоз у грудничков появляется в складочках на ножках, на ягодицах и в области паха. Предшествуют этому опрелости, нахождение в памперсе слишком длительное время, плохая гигиена и неподходящая (синтетическая, слишком тесная) одежда.
Лечение детского кандидоза
Если грибы рода Кандида начали патогенный процесс в ротовой полости ребенка, лечение, как правило, проводят местно. Заключается оно в обработке мест, где наблюдается белый налет, специальными препаратами. Раньше врачи приписывали смазывать ребенку рот зеленкой. Это лекарство хорошо помогает, но сушит слизистые. Сейчас применяют «Акридерм», «Фукорцин», растворы буры в глицерине.
В целях профилактики нужно в первые месяцы жизни грудничка кипятить соски и бутылочки, мыть погремушки. Мама должна перед кормлением обрабатывать соски противогрибковыми препаратами.
При симптомах дисбактериоза сдают кал грудничка на бакпосев. Считается, что грибы рода Кандида в кале у детей возрастом до 12 месяцев могут присутствовать в количествах не более 103КОЕ/г, а старше 12 месяцев в количестве 104КОЕ/г. Если показатель превышен, назначают препараты, восстанавливающие микрофлору и укрепляющие иммунитет.
Если вышеуказанные методы лечения не помогают, ребенку проводят дополнительное обследование и назначают противогрибковую терапию.
Кандидоз у женщин и мужчин
У взрослых грибы Кандида могут, как и у детей, инфицировать ротовую полость, кожу, кишечник. Кандидоз во рту проявляется творожистым налетом, захватывающим язык, десна, нёбо, внутреннюю сторону щек и сопровождается болезненными ощущениями. Иногда слизистые изъязвляются.
Кандидоз на коже характерен красными пятнами в местах внедрения гриба (под мышками, под грудями у женщин, в паху, реже под коленками). Эти пятна зудят и шелушатся, а при расчесах изъязвляются. Но чаще всего взрослые страдают от кандидоза мочеполовых органов.
У женщин грибы селятся в вагине и на вульве, поэтому заболевание назвали вульвовагинит. На начальных этапах его симптомы следующие:
— белые (как кислое молоко) влагалищные выделения;
— зуд, не проходящий, а, наоборот, усиливающийся после подмывания и по утрам;
— неприятный запах нижнего белья;
— боль при половом акте.
Самый показательный симптом – грибы рода Кандида в мазке, взятом из влагалища.
Без лечения признаки заболевания усугубляются. Появляются боли не только при половом акте, но и при каждом мочеиспускании, слизистая влагалища отекает, изъязвляется, выделения становятся более густыми.
У мужчин инфицирование кандидой называется баланопоститом. Симптомы:
— выделения творожистого вида из полового органа;
— зуд, боли при мочеиспускании;
— болезненность полового акта.
Кроме мочеполовой системы, грибы Кандида паразитируют на наружных органах людей. Инфицирование ногтей называется «онихия», а приногтевого валика — «паранихия». Причинами этих заболеваний могут стать заусеницы, выполнение маникюра инфицированными инструментами.
Анализ на грибы рода Кандида
Наличие кандидоза устанавливают по результатам таких исследований:
— мазок из ротовой полости либо влагалища;
— посев;
— ИФА;
— ПЦР.
Дополнительно доктор может назначить анализы мочи и крови.
Если мазок планируют брать из влагалища и/или уретры, не разрешается перед этим подмываться, а мочиться можно только за 2 часа до взятия мазка, не позже. Если мазок планируют брать изо рта, запрещается перед этим чистить зубы.
Для проведения посева используют кал, мокроты, мочу, соскобы с пораженных участков кожи и слизистых. Через трое суток получают ответ, есть или нет в материале грибы рода Кандида. Норма – это отрицательный результат. Если анализы подтвердят наличие грибка, определяют его вид и чувствительность к медпрепаратам.
Наиболее точным считается анализ ПЦР, что значит полимерно-цепная реакция молекул ДНК гриба. Он определяет наличие патогена даже на самой начальной стадии заболевания. Материалом для ПЦР служат мокроты, выделения, кровь.
Лечение
Если у пациента обнаружены грибы рода Кандида, лечение проводят медикаментозное. Внутрь выписывают:
— «Флуконазол».
— «Низорал».
— «Дифлюкан».
Наружно используются мази:
— «Клотримазол».
— «Сертоканазол».
— «Миконазол».
— Свечи с пумафицином и другие средства, подавляющие рост грибка. Могут быть назначены и противовоспалительные мази.
Лечение беременных проводят только наружными средствами. Лишь в отдельных случаях назначается «Пумафицин» перорально.
При кандидозе мочеполовых путей проводится лечение обоих половых партнеров.
Дополнительно к противогрибковым препаратам назначаются витамины и другие средства, укрепляющие иммунитет.
Источник: http://fb.ru/article/316101/drojjepodobnyie-gribyi-roda-kandida
Поделиться: